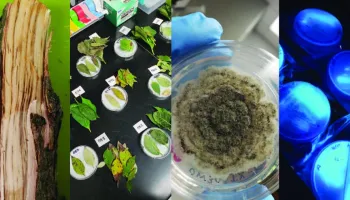
University of Maryland Plant Diagnostic Laboratory Reopens

Ana Cristina Fulladolsa Palma
Ana Cristina Fulladolsa Palma
Assistant Research Professor
Graduate Program Affiliations
Education
Ph.D., University of Wisconsin-Madison
B.S., University of San Carlos de Guatemala, 2009
Latest Papers
Detection and Quantification of Spongospora subterranea Sporosori in Soil by Quantitative Real-Time PCR
|
Plant Disease
Author(s): Ipsita Mallik, Ana Cristina Fulladolsa, S. K. R. Yellareddygari, Francisco G. Bittara, Amy O. Charkowski, Neil C. Gudmestad